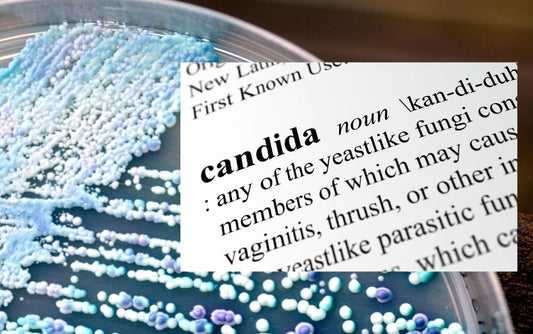

Abigail's Oven Blog

Sourdough, the Utah Pioneers, and Western Migra...
Sourdough bread has a long and notable history, dating back to ancient Egypt. But it was during the American Westward Expansion that sourdough bread truly came into its own. This...
Sourdough, the Utah Pioneers, and Western Migra...
Sourdough bread has a long and notable history, dating back to ancient Egypt. But it was during the American Westward Expansion that sourdough bread truly came into its own. This...

What Customers Want to Know About Eating Abigai...
Four times a year, on the third Friday of each quarter (January, April, July, October), has been designated as #GetToKnowYourCustomersDay. So today we invite you to our Instagram page to share your personal Abigail's...
What Customers Want to Know About Eating Abigai...
Four times a year, on the third Friday of each quarter (January, April, July, October), has been designated as #GetToKnowYourCustomersDay. So today we invite you to our Instagram page to share your personal Abigail's...
How Sourdough Can Help With Candida
There are a number of things that can help to control Candida overgrowth, including diet, lifestyle changes, and medication. Sourdough bread is one food that has been shown to be...
How Sourdough Can Help With Candida
There are a number of things that can help to control Candida overgrowth, including diet, lifestyle changes, and medication. Sourdough bread is one food that has been shown to be...

How to Bake Sourdough Bread in a Barbeque
Baking bread in a home BBQ is a great way to get a crispy crust and a chewy interior. It's also a fun challenge to use your BBQ during the summer months. But...
How to Bake Sourdough Bread in a Barbeque
Baking bread in a home BBQ is a great way to get a crispy crust and a chewy interior. It's also a fun challenge to use your BBQ during the summer months. But...

Beat the Heat with Crock Pot Baked Sourdough
A slow cooker is a convenient way to bake bread in the summer without heating up your kitchen. And you can even bake bread in a Dutch Oven on your outdoor barbecue. This...
Beat the Heat with Crock Pot Baked Sourdough
A slow cooker is a convenient way to bake bread in the summer without heating up your kitchen. And you can even bake bread in a Dutch Oven on your outdoor barbecue. This...

My Sourdough Addiction; Is It Really All That Bad?
If you're thinking about getting into sourdough baking, be warned: it can be addictive! But it's also a lot of fun, and the results are delicious. This post reports on...
My Sourdough Addiction; Is It Really All That Bad?
If you're thinking about getting into sourdough baking, be warned: it can be addictive! But it's also a lot of fun, and the results are delicious. This post reports on...
